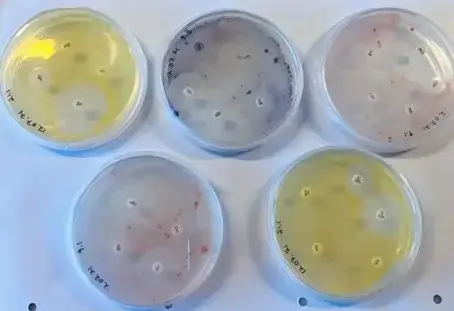

Svalbards økosystemer er svært sårbare for klimaendringer og forurensning, men Arktis mangler fortsatt en helhetlig overvåkning av sitt mikrobielle liv. Dette er et betydelig kunnskapshull fordi mikroorganismer driver essensielle biogeokjemiskeprosesser og reagerer raskt på miljøendringer - noe som gjør dem til kraftige tidlige varslingsindikatorer. Samtidig ugjør fremveksten av gener for antibiotikaresistens nye risikoer for både økosystemer og mennskers helse.
Lise Øvreås er professor i geomikrobiologi ved Universitetet i Bergen og professor II ved Universitetssenteret på Svalbard (UNIS). Hun deltar i studien av bakterier i Adventfjorden sammen med forskerne Manish Prakash Victor og Nachiket Marathe fra Havforskningsinstituttet.
– Studien vår tyder på at det arktiske mikrobesamfunnet kan bli en kilde for framvekst av «superbakterier», sier Manish Prakash Victor.
Foredraget vil holdes på engelsk.